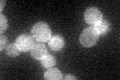
YKR003W
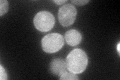
YKR003W
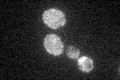
YKR003W

View description
Member of an oxysterol-binding protein family with overlapping, redundant functions in sterol metabolism and which collectively perform a function essential for viability; GFP-fusion protein localizes to the cell periphery
Localization:
Intensity:
Fold change:
Significance:
-
C’ GFP library in SD
cell periphery34.07 -
N' NOP1pr-GFP in SD

N/A0 -
N' TEF2pr-mCherry in SD

N/A0 -
N' NATIVEpr-GFP in SD

N/A0 -
N' TEF2pr-VC and Cyto-VN in SD

N/A0 -
C’ GFP library in SD+DTT
cell periphery46.911.37Yes -
C’ GFP library in SD+H2O2

cell periphery41.941.23No -
C’ GFP library in Starvation Media
cell periphery36.661.07No -
C’ GFP library on the background of Pup2-DaMP

N/A -
C’ GFP library on the background of CCT mutant

N/A0N/AYes
